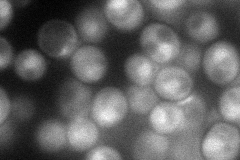
YPL096W
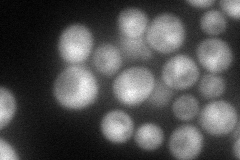
YPL096W
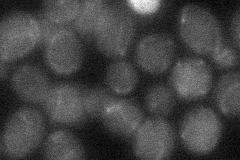
YPL096W
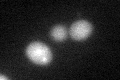
YPL096W

View description
Conserved peptide N-glycanase required for deglycosylation of misfolded glycoproteins during proteasome-dependent degradation; localizes to the cytoplasm and nucleus; activity is enhanced by interaction with Rad23p
Localization:
Intensity:
Fold change:
Significance:
-
C’ GFP library in SD

below threshold18.52 -
N' NOP1pr-GFP in SD
cytosol,nucleus76.3438 -
N' TEF2pr-mCherry in SD
nucleus85.9823 -
N' NATIVEpr-GFP in SD

below threshold23.4637 -
N' TEF2pr-VC and Cyto-VN in SD
below threshold24.1225 -
C’ GFP library in SD+DTT
cytosol23.141.24No -
C’ GFP library in SD+H2O2

cytosol21.711.17No -
C’ GFP library in Starvation Media

cytosol34.291.85No -
C’ GFP library on the background of Pup2-DaMP

below threshold -
C’ GFP library on the background of CCT mutant

below threshold17.5750.948758No
